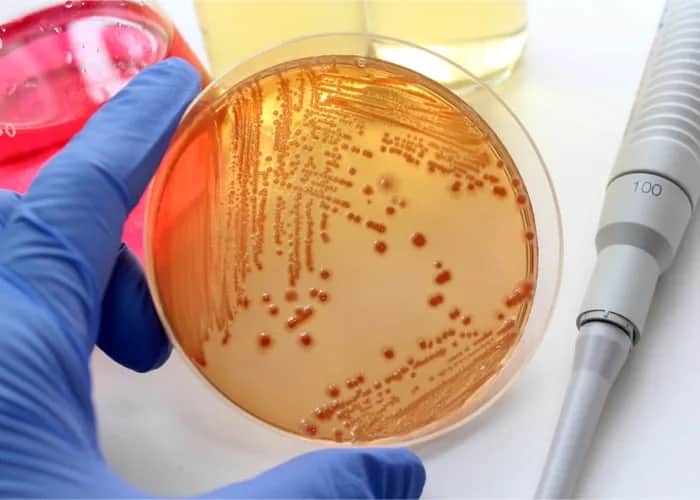
Wysokie CRP przyczyny: Co może wskazywać na poważne problemy zdrowotne?

Zimne dłonie przyczyny mogą być alarmujące. Sprawdź, co je powoduje i kiedy warto skonsultować się z lekarzem, aby zadbać o zdrowie.
Zimne dłonie przyczyny mogą być alarmujące. Sprawdź, co je powoduje i kiedy warto skonsultować się z lekarzem, aby zadbać o zdrowie.
Poznaj najczęstsze przyczyny nadmiernych gazów jelitowych oraz skutki zdrowotne. Dowiedz się, jak dieta i styl życia wpływają na dyskomfort.
Poznaj najczęstsze przyczyny krwotoku z nosa i skutki, które mogą prowadzić do tego problemu. Dowiedz się, jak ich unikać i dbać o zdrowie nosa.
Poznaj przyczyny powstawania kamieni nerkowych i skuteczne metody ich unikania. Dowiedz się, jak dbać o zdrowie nerek i unikać bólu.
Poznaj przyczyny bólu pięty i ich objawy. Dowiedz się, jak skutecznie leczyć ból pięty oraz jakie metody mogą przynieść ulgę w codziennym życiu.
Poznaj przyczyny udaru mózgu i dowiedz się, jak uniknąć zagrożeń oraz ryzykownych czynników, które mogą prowadzić do tego poważnego schorzenia.
Poznaj przyczyny senności w ciągu dnia i dowiedz się, jak poprawić jakość snu. Zrozum, co wpływa na Twoje samopoczucie i energię.
Zrozum, jakie są ginekologiczne przyczyny wzdętego brzucha i kiedy warto szukać pomocy. Dowiedz się więcej o objawach i ich znaczeniu.
Poznaj przyczyny wysokiego CRP i dowiedz się, co może oznaczać dla Twojego zdrowia. Zrozum, jak stan zapalny wpływa na organizm.
Poznaj kluczowe przyczyny wojny secesyjnej, różnice gospodarcze i społeczne między Północą a Południem, które doprowadziły do tego tragicznego konfliktu.